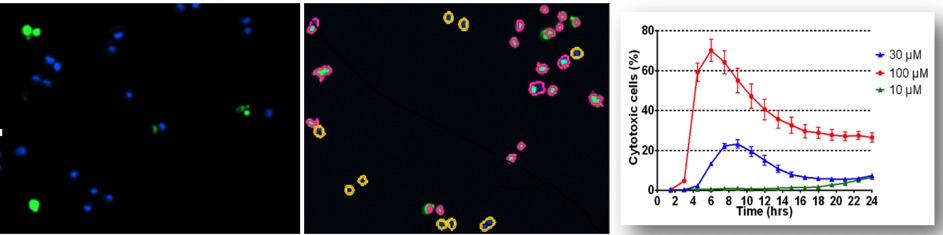

Cytation5智能微孔板检测系统仪器简介
一、主要配置模块及功能介绍:
1. Cytation5PW:主机系统;
1)配备高分辨明场成像、相差成像、荧光成像、3D成像功能,具备实时、分时成像功能;相差成像适用于元代细胞等无标记成像分析;
2)宽场成像:宽场16bit CMOS成像,速度是传统3-4倍;
3)温控:多点梯度控温,防凝结及水雾;
2. 样品适配器:适用于微孔板、载玻片,T25细胞培养瓶、35mm、60mm细胞培养皿等样本检测;
3.气体控制模块:CO2、O2双气孔,适用于常规及低氧活细胞分析。
?4.物镜:6个;长工作距离,自带聚焦校准环,同轴聚焦技术,切换镜头无需在聚焦调节。其中荧光物镜:明场、荧光成像;相差物镜:无标记相差成像;
???? 5.激发光源:4组,四色荧光成像;一体化集成Cube,包括LED激发光源、截止滤光片、激发滤光片、检测滤光片、分光光路等;
6.聚焦方式:配备自动图像聚焦和激光聚焦双模式,适合不同实验要求。自动图像聚焦:自动、实时寻找最佳聚焦面,适合于普通微孔板、低倍镜成像,优点:耗材适用面广、要求低、细胞状态要求低,可用于Trans-Well小室成像。缺点:速度较慢;激光聚焦:基于激光快速焦面聚焦,速度快、聚焦更精准。适用于快速、高倍高分辨精细成像。缺点:需要玻璃底微孔板、载玻片等;
7.载物台:高精度载物台,全自动高通量微孔板检测,保证每一成像时间、每一样
本视野固定,避免细胞非均匀生长带来的检测误差;
8.遥感控制器:灵活、方便成像区域等设定;
9.双通道在位加样系统:自动在位加样,实现自动加液、加药等,用于钙流、GPCR等快速动力学、瞬时成像等;
10.高内涵高端分析软件:包含全套高内涵分析功能,具备反卷积分析、双选域分析、蒙太奇拼接等高端分析功能;
二、 主要功能:
用于长时间、动态的活细胞形态、亚结构、细胞生理、功能、分化等研究,包括:
1.细胞生理、生化:包括细胞钙流、细胞运动、粘附、膜电位;细胞骨架、细胞亚结构动态变化;DNA损伤、细胞转染、核异位;低氧诱导等;
2.细胞生物学及肿瘤生物学:细胞周期、凋亡、增值;细胞迁移、侵染;细胞吞噬、自噬、外泌体转移、细胞杀伤等;基因定位、药物与靶分子共定位及互作;CAR-T细胞杀伤等;
3.组织学:3D微组织、类器官培养;组织成像及图像拼接,微组织细胞功能分化、异质性;血管、神经等分化及生成;药物等组织定位;
4..模式生物:小型模式生物发育等;
三、主要经典应用简介:
该系统在基础科研、转化医学及药物研发中的应用主要包括:
细胞增殖:细胞增殖是判定细胞活力、增殖能力的最常用也是重要指标,是培养细胞生物学特性的基本参数。Cytation5PW配备齐备的环境控制系统包括:CO2、O2、温度等,以及高分辨率宽场快速成像分析系统可高通量、长时间、实时进行细胞计数并绘制生长曲线。并配备相差光路,除荧光成像检测外,对于元代细胞还可进行高分辨明场、无标记相差增值检测。同时,结合在位双通道加样系统,可以实时、自动化检测药物刺激、低氧环境等细胞增殖等变化。

另外,Cytation5PW配备高精度载物台,保证高通量检测时每个时间点、每个样本视野固定,避免因为细胞生长不均一造成的计数差异,生长曲线更精确。
2. 细胞迁移:划痕实验是细胞迁移能力、组织损伤修复、细胞功能检测的重要方式,Cytation5PW配备XY轴扫描成像及Z轴层切成像功能,可在2D、微组织3D水平检测和分析细胞迁移能力。

3.细胞毒性分析:
细胞毒性的评估在药物作用和治疗方法评价中非常重要,Cytation5PW可采用CellToxTM Green及Hoechst33342联合检测,检测活细胞、受损细胞、死细胞等,准确评估细胞毒性。
4.细胞侵染:Trans-well是检测细胞尤其是肿瘤细胞侵袭能力的最重要指标,由于Trans-well小室、侵染穿孔细胞分属不同层面,一般成像设备均无法进行自动Trans-well实验,Cytation5PW配备超长工作距离物镜,自动图像聚焦、激光聚焦多种聚焦模式,可以自动、实时检测Trans-well细胞,评估侵袭能力。

5.细胞周期、凋亡、分裂:细胞生物学最经典最常用检测技术,Cytation5PW直接以细胞核成像方式,通过检测荧光标记的DNA量变化,直接、准确进行周期分析。

通过高分辨率细胞成像,还可以进行凋亡小体、有丝分裂等分析
?
6.细胞线粒体膜电位:线粒体膜电位是细胞早提凋亡重要手段。通过线粒体标记、膜电位指示荧光的强度变化准确评估线粒体膜电位高低。从而评估早期凋亡的发生。

7.细胞杀伤:细胞杀伤是细胞治疗、免疫细胞功能研究等重要评估手段,CAR-T细胞杀伤已成为研究热门。结合无标记相差成像、多色荧光成像、3D层扫成像,Cytation5PW可在2D、3D层面进行CAR-T等细胞杀伤实验,评估细胞治疗效果,尤其是微组织3D杀伤实验可完美模拟体内杀伤实验。

8.细胞低氧研究:最新2019年诺贝尔奖获得项目,也是现在研究热点。Cytation5PW配备CO2、O2双气体控制系统,结合细胞成像可进行细胞渐进氧反应等多种低氧环境细胞实验及模拟肿瘤组织低氧实验。

9.外泌体摄取:外泌体摄取与肿瘤转移紧密相关。外泌体极小,Cytation5PW通过高分辨成像系统、高内涵分析系统可以实时分析不同细胞、不同状态下外泌体摄取量。

10.细胞自噬:“细胞自噬机制的发现”获得2016年度的诺贝尔生理学或医学奖,是细胞学研究热门之一。Cytation5PW通过高质量成像及反卷积分析,避免荧光信号的干涉、衍射的干扰,清晰捕捉LC3蛋白颗粒,准确检测每个细胞自噬小体数量,结合高内涵分析软件建立自噬相关机制的研究和药物筛选方法。

10. 钙闪、钙离子检测:钙信号是胞内细微波动中最重要的一员。钙信号常常作为第二信使发挥其“火炬传递”的功能(例如GPCR信号通路),信号波动激发往往在瞬间完成且胞浆钙离子浓度呈规律性变化,在肌肉收缩、细胞分泌、卵子授精、神经传导、个体发育、细胞凋亡等生理病理过程中,发挥关键的调控作用。
Cytation5PW配备双通道在位加样系统,可以完美解决钙离子瞬时检测。

12. GPCR信号通路检测:GPCR 信号通路是目前细胞内最重要的信号通路,与大量疾病相关,约占市场上药物靶点的40%份额, Cytation5PW依据GPCR 信号通路中的第二信使生物传感器,结合成像技术可以获得更多表型方面的数据。由于第二信使的释放是比较快,因结合自动加样器,更适用于实时检测,可以更好的检测第二信使水平变化。还可用于GPCR第二信使DAG和Ca2+的浓度变化同步检测。

13.基因定位及药物共定位:靶分子及药物共定位是细胞层面分子互作,靶标及药物特异性、疾病及药物机理研究的重要手段。Cytation5PW借助双通道加药系统、高质量图像、多色通道及高内涵分析系统可完美进行共定位分析。

14. DNA损伤:彗星试验(Comet Assay)又称单细胞电泳(Single cell gel electrophoresis,SCGE),是一种在单细胞水平上检测DNA损伤与修复的方法。兼具快速、灵敏的优点,彗星试验被广泛应用于生物学、临床和毒理学等科研领域。Cytation5PW依靠精确的图像定量分析,轻松实现高通量的基因毒性检测。
??
15. 3D细胞培养及检测:3D细胞培养是为了在细胞培养过程中形成微组织,模拟更加接近体内生存条件的微环境,克服传统贴壁细胞的不足,模拟研究细胞在体内的功能分化和生理、机能差异,在转化医学、干细胞领域、肿瘤研究等领域都有重要的应用前景。
Cytation5PW具备多色荧光成像及层切3D成像功能,其环境控制也非常齐全和精确,可确保微组织长时间成像检测及分析。
16. 细胞分化和组织器官生成:Cytation5PW可全程动态监测细胞分化及组织形成,并可评估分化能力。如血管生成、神经细胞生长和分化等。

17.模式生物、组织形态及药物定位:利用Cytation5PW的蒙太奇图像拼接功能,可以进行组织、小型模式生物的成像,用于药物定位、模式生物发育等研究。
